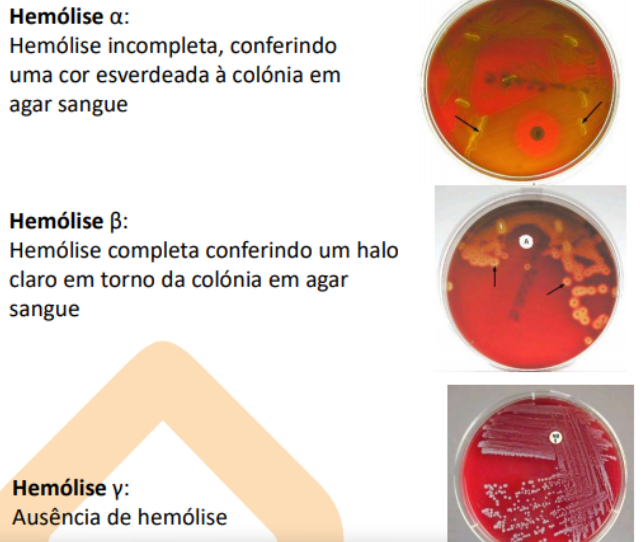

Classificação da familia Streptococcacea


Características gerais dos Streptococcus e Enterococcus (7)
- Cocos;
- Imóveis;
- Gram +;
- Catalase - (≠ staphylococcus);
- Em pares ou cadeia;
- Não esporulados;
- Nutricionalmente exigentes (5-10% CO2).

Quais são os padrões de hemólise possíveis dos Streptococcus?
- Alfa hemólise: incompleta - cor esverdeada;
- Beta hemólise: completa - halo claro/transparente;
- Gamma hemólise: ausente.
Como se classificam os Streptococcus segundo a classificação de Lancefield?
Os que fazem beta hemólise:
- Grupo A: S. pyogenes;
- Grupo B: S. agalactiae. (mnemónica: B>Breast>Agalactiae)

Quais os Streptococcus que fazem beta hemólise?
S. pyogenes;
S. agalactiae (pode fazer gamma).
[Mnemónica: “Beta não diz PA”]

Quais os Streptococcus que fazem alfa hemólise?
- S. pneumoniae;
- Grupo viridans (alfa ou gamma).

Quais os Streptococcus que se subdividem segundo a classificação de Lancefield?
Os beta hemolíticos:
- S. pyogenes; - Grupo A
- S. agalactiae. - Grupo B

Quais os Streptococcus principais? (4)
- S. pyogenes;
- S. agalactiae;
- S. pneumoniae;
- S. viridans.
Quais as proteínas específicas visadas como marcadores para S. pyogenes?
Proteínas M e T.
Há vários tipos de proteínas M - daí a recorrência de laringites (infecções de recorrência por ausência de imunidade adaptativa)

Epidemiologia S. pyogenes
- Só coloniza Homem;
- Coloniza orofaringe e pele (5-15% população assintomática).
- Transmissão:
- Gotículas secreções respiratória;
- Contacto direto;
- Populações de risco: Crianças e adolescentes.

Fatores de virulência S. pyogenes (5)
- Exotoxina pirogénica (A,B,C) termolábel [escarlatina];
- Estreptolisina O e S [Mnemónica: pyOgeneS];
- Estreptoquinase (fibrinolisina);
- Desoxirribonuclease;
- Hialuronidase.

Apresentação Clínica S. pyogenes
Supurativas:
- Faringite
- Amigdalite recorrente
- Escarlatina
- Erisipela
- Impetigo
- Fasceite necrosante
- Bacteriemia
- Síndrome choque tóxico
Não supurativas: (mecanismos imunológicos - não está relacionado com a ausência de bacterias como nos estafilacocos).)
- Febre reumática
- Glomerulonefrite

Terapêutica S. pyogenes
Penicilina;
Se houver alergia à penicilina -> Macrólidos (eritromicina, claritromicina, azitromicina); Mas aqui já podemos encontrar resistência

Epidemiologia S. agalactiae
Coloniza trato GI, urinário e genital (30% mulheres têm S. agalactiae na vagina). Agente neonatal - 60% bebés de mãe colonizada ficam colonizados.
[Mnemónica: agalactiae -> leite -> amamentação -> período neonatal]

Qual a apresentação clínica do S. agalactiae?
Período neonatal:
- EOD (Early Onset Disease): Pneumonia, Meningite e Sépsis; (PreMaturoS)
- LOD (Late Onset Disease): Sépsis e Meningite;
Mulher Grávida;
- ITU
- infeção pós parto;
Adulto:
- ITU
- Infecção da pele e tecidos moles
- bacteriemia.

Qual o mecanismo de prevenção de infecção no recém-nascido por S. agalactiae?
Rastreio obrigatório grávidas às 35/37 semanas. Se estiverem colonizadas, faz-se antibioterapia intraparto.

Qual a apresentação clínica do S. viridans?
Cárie dentária; Endocardite;
(neste caso endocardite em valvula não prostática, por opoição ao estafilococos)
- São comensais das vias aéreas superiores, têm baixo poder patogénico => efeito competitivo entre bactérias e protege.
(mnemónica: viriDANS>DENS>DENTE>CÁRIE)

Quais as espécies pertencentes a S. viridans?
- S. mitis;
- S. mutans;
- S. salivarus;
- S. sanguis.
Como distinguir S. viridans de S. pneumoniae?
Os S. viridans são resistentes à optoquina = crescem num meio em que esta esteja presente.
Características gerais S. pneumoniae (7)

- Diplococcus de cadeia curta; Lanceolados;
- Hemólise alfa;
- Inibidos por optoquina;
- Nutricionalmente exigentes: 5-10% CO2;
- Solúveis em bílis: não crescem no intestino.

Epidemiologia S. pneumoniae (5)
- Doença geralmente após aquisição de novo serogrupo e frequentemente precedida por infecção virica respiratória (pneumonia)
- Grupos de risco: idosos, crianças, imunocomprometidos;
- Transmissão oral-oral;
- Crianças com alta colonização podem ser assintomáticas.
- Uma das principais causas de otite média

Apresentação clínica de S. pneumoniae
- Meningite;
- Pneumonia;
- Otite média;
- Sinusite;
- Mastoidite;
- Bacteriemia oculta.

Terapêutica S. pneumoniae
Infeções respiratórias:
- Penicilina- terapêutica de eleição
- Macrólidos se alergia e Moxifloxacina se resistência
Meningite, bacteriemia:
- Penicilina;
- Cefalosporina 3ª geração (cefotaxima);
- Vancomicina.
Vacina para meningites: idade pediátrica.

Qual a espécie de Streptococcus que pode ser identificado pelo CAMP test?
S. agalactiae: há cruzamento da colónia com S. aureus.
[Mnemónica: CAMP -> agalaCtiae]



